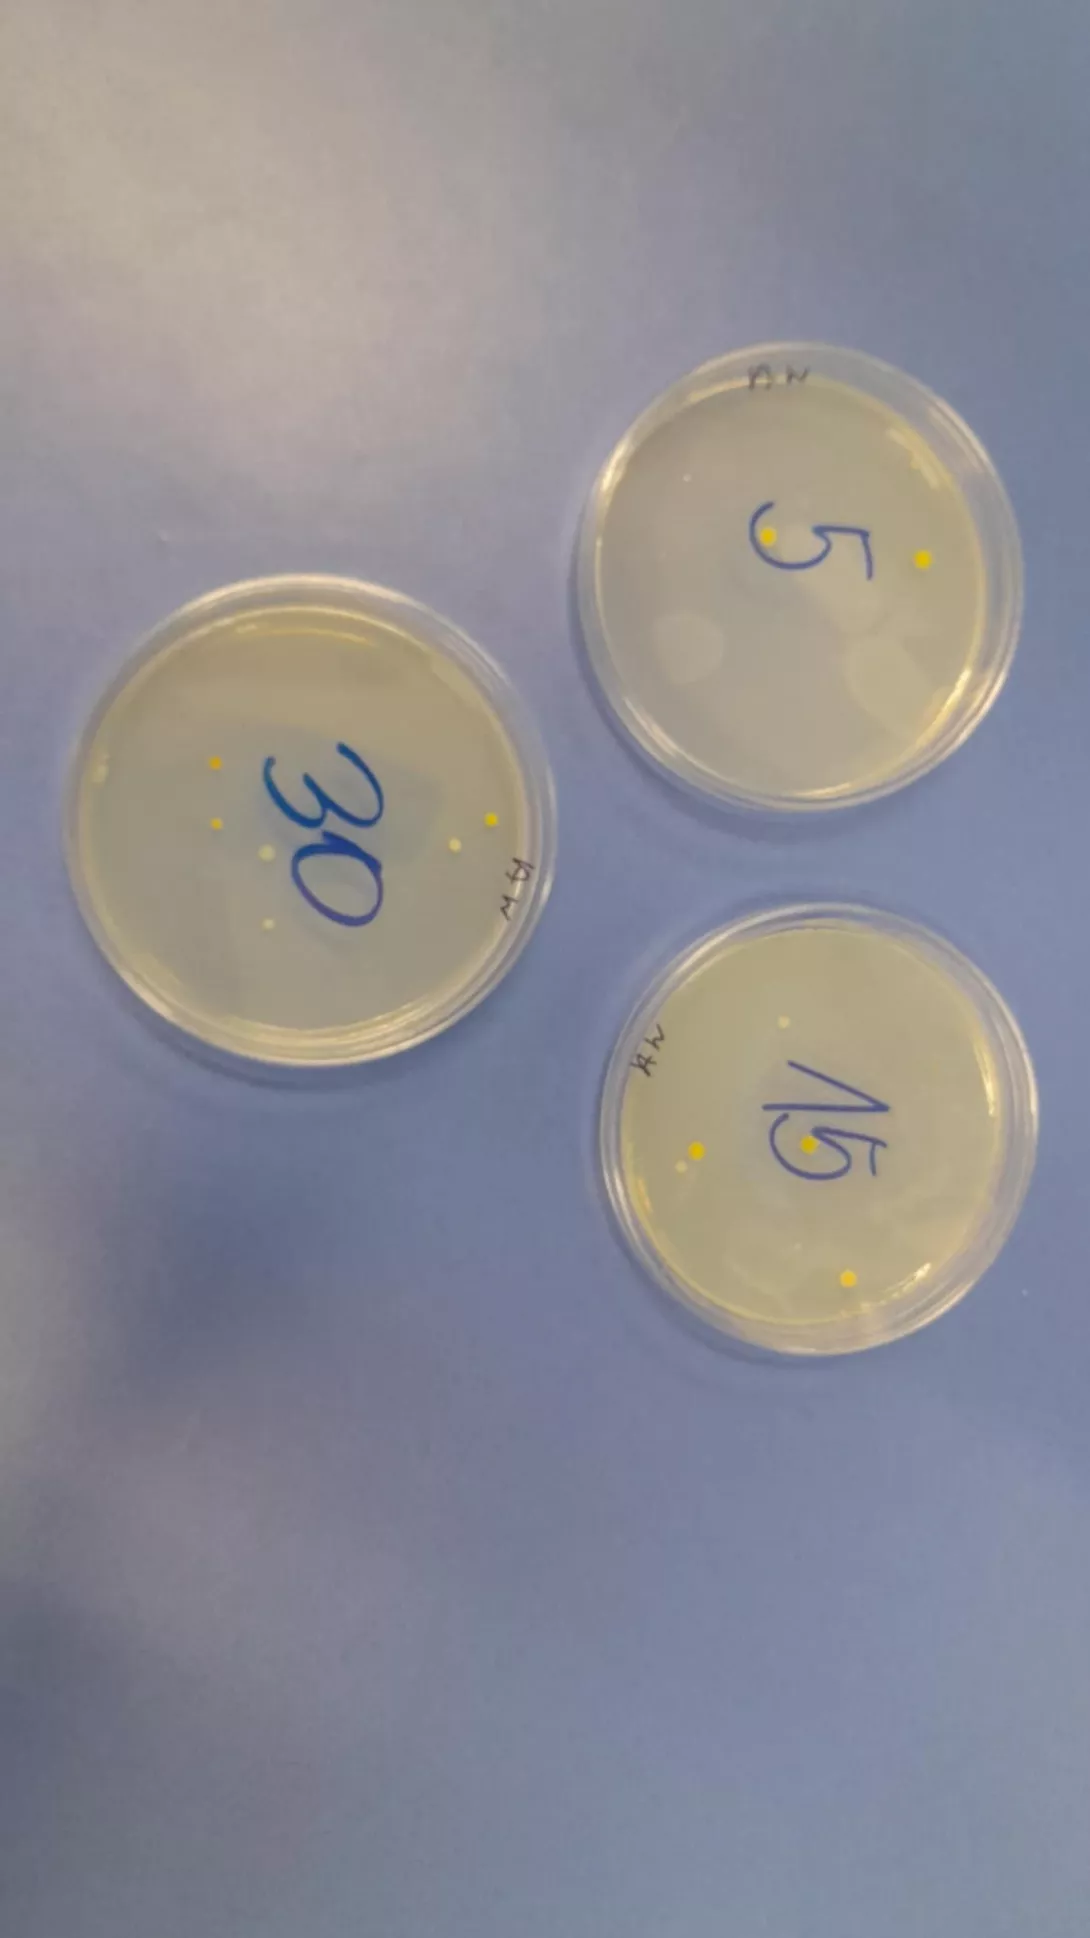
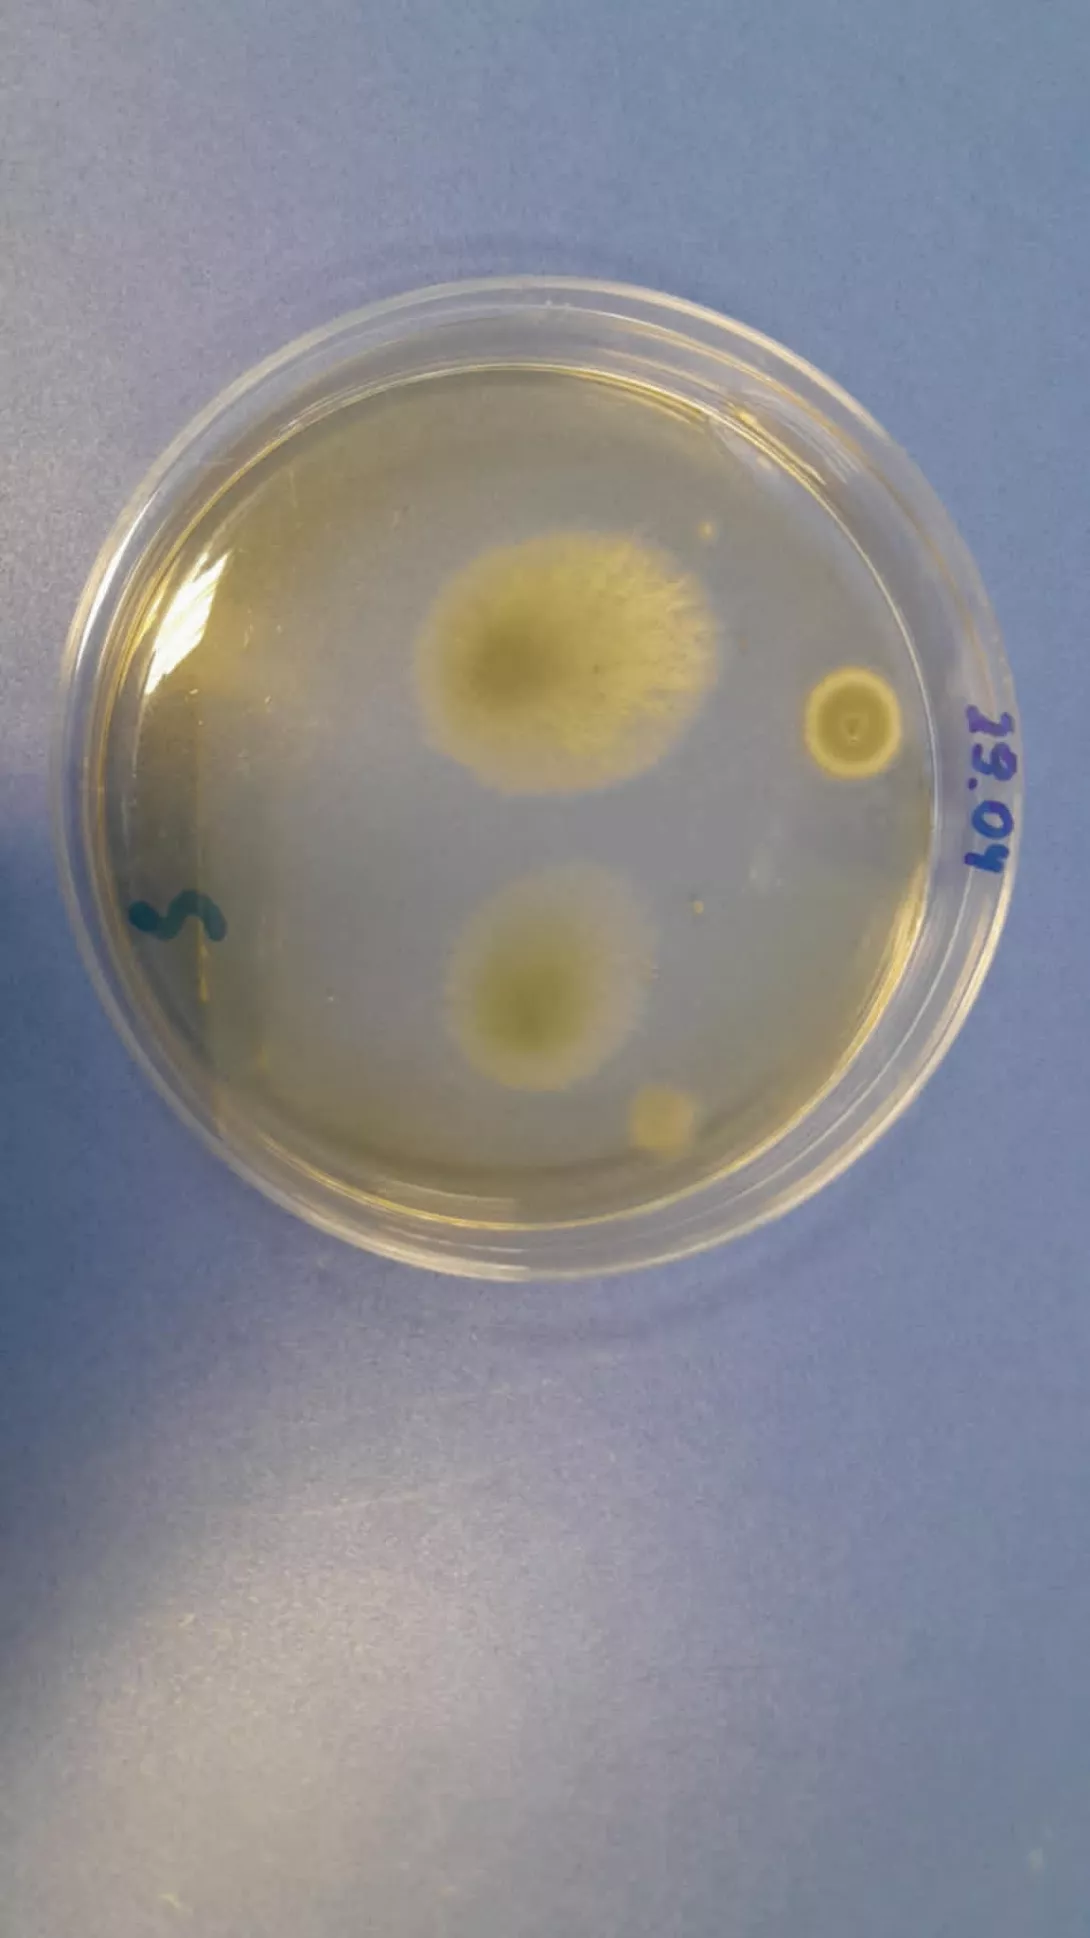

Warsztaty biologiczne na Politechnice Łódzkiej
Marcin Paździor
1 maja 2025 r.

29 kwietnia uczniowie rozszerzający biologię pod opieką pani Dominiki Franoszek uczestniczyli w warsztatach na Wydziale Inżynierii Procesowej i Ochrony Środowiska PŁ. Zajęcia dotyczyły monitoringu czystości mikrobiologicznej w miejscu pracy. Pani dr inż. Anna Antecka zapoznała uczniów z metodologią badań, najnowocześniejszym sprzętem laboratoryjnym. Poznaliśmy normy dla powietrza atmosferycznego i wewnątrz pomieszczeń mieszkalnych. Obserwowaliśmy hodowle różnych bakterii, drożdży i pleśni. Uczniowie samodzielnie pobierali różne próby z otoczenia w celu identyfikacji drobnoustrojów metodą hodowlaną.
Dominika Franoszek